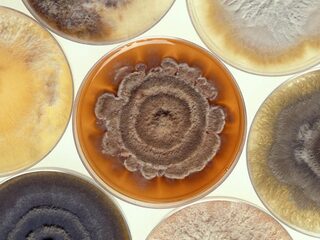
Dragen we straks kleding van schimmels?

Nieuws
Wetenschap & Techniek
- Nieuws
- Wetenschap & Techniek
- Nieuws en CoNOS/NTR
Worden de jaren twintig het decennium van de oceanen?
- Nieuws en CoNOS/NTR
Waarom tsjilpende vogels zich vaker te pletter vliegen
- Nieuws en CoNOS/NTR
Record aantal verminkte dolfijnen aan de Franse kust aangespoeld
- Nieuws en CoNOS/NTR
'Overgewicht bij kinderen stap voor stap aanpakken'
- FocusNTR
Dragen we straks kleding van schimmels?
- Nieuws en CoNOS/NTR
Deep learning is overal om ons heen
- Nieuws en CoNOS/NTR
'Vermissing is nooit klaar'
- SpraakmakersKRO-NCRV
Robbert Dijkgraaf over meldpunt Forum voor Democratie: 'totaal verkeerd initiatief'
- EenVandaagAVROTROS
Waarom zijn minder vrouwen toponderzoeker?
- Nieuws en CoNOS/NTR
Ook op latere leeftijd maak je nog nieuwe hersencellen aan
- Nieuws en CoNOS/NTR
Naturalis gaat reusachtige langnekdino’s opgraven
- Nieuws en CoNOS/NTR
Naturalis wil botten langnek-dinosaurus naar Leiden halen